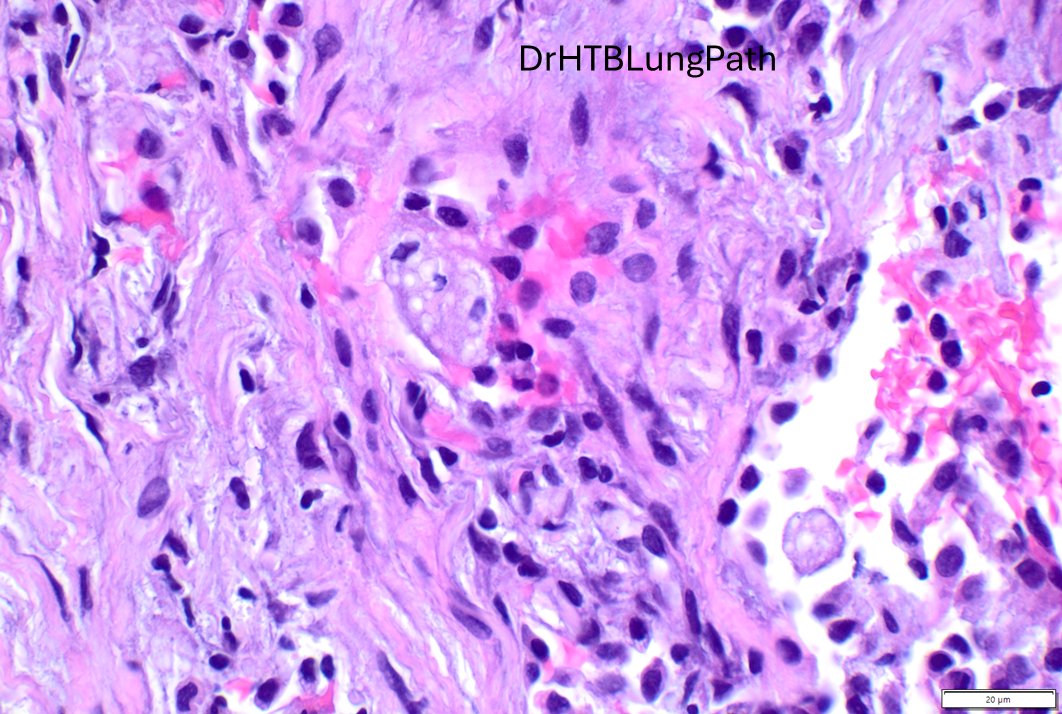
Humberto Trejo Bittar, MD, FCAP tweet media

Humberto Trejo Bittar, MD, FCAP
138 posts

Humberto Trejo Bittar, MD, FCAP
@drHTBlungpath
Thoracic Pathologist | Section Head | Fellowship Director | | Lung Cancer Research | Educator & National Speaker @Moffitt #LungCancer #MedEd #lungpath #path





Just out in AJSP – a paper from our group describing a MAJOR new oddity. Tumors that normally arise in the jaw from tooth🦷precursors (ameloblastoma) – but as lung primaries 🫁! This was a neat collaboration b/w MSKCC, Mayo and UTSW where these cases were encountered independently, and we put our heads together with the help of original contributors and fellows to tackle this puzzle. Time will tell if these are truly exceptional or have been underrecognized. journals.lww.com/ajsp/fulltext/… @JLHornick @ENTpathology @MSKPathology @PulmPathSoc @yro854 @thoracicpath @Path_Matt @SansanoValero @AndreMo77438628